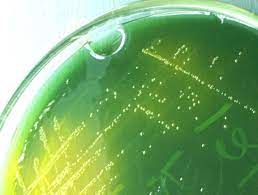

티스토리 뷰
목차
겨울에도 패혈증을 조심해야 하는 이유 추운 겨울철, 많은 사람들이 감기나 독감에 걸리기 쉽다고 생각하지만, 그보다 더 위험한 감염 질환이 있습니다. 바로 패혈증(sepsis)입니다.
패혈증은 세균, 바이러스, 곰팡이 등 다양한 감염 원인이 一몸속에 퍼지면서 면역 체계가 과도하게 반응하여 전신 염증 반응을 일으키는 치명적인 질환입니다. 일반적으로 비브리오패혈증은 여름철 바닷물에서 감염되는 경우가 많아 겨울에는 걱정할 필요가 없다고 생각할 수 있습니다.
77
77
겨울철 감염병 노로바이러스 증상 치료 예방법
노로바이러스는 가장 흔하면서도 과소평가된 건강 위협하는 질병 중 하나이며, 특히 겨울철에 그렇습니다. 이 전염성이 매우 강한 바이러스는 오염된 음식, 물, 표면, 심지어 사람과 사람 간의
woori.ssugaengi.com
그러나 겨울철에도 다양한 감염원이 존재하며, 특히 고령자, 만성질환자, 면역력이 약한 사람들은 사소한 감염이 빠르게 패혈증으로 악화될 수 있어 각별한 주의가 필요합니다. 겨울철에는 추운 날씨로 인해 실내에서 생활하는 시간이 길어지면서 호흡기 감염(폐렴, 독감)이 증가하고, 수분 섭취가 줄어들어 요로 감염 위험도 높아집니다.
또한, 피부가 건조해지면서 상처 감염의 가능성이 커지고, 겨울철에도 발생할 수 있는 노로바이러스, 식중독이 패혈증을 유발할 수도 있습니다. 특히 패혈증은 초기 대응이 늦어지면 다발성 장기부전, 쇼크로 이어질 수 있어 생명을 위협하는 응급 질환입니다.
따라서 감염을 조기에 예방하고, 증상이 나타나면 신속하게 대응하는 것이 무엇보다 중요합니다. 이번 글에서는 겨울철 발생할 수 있는 주요 패혈증 원인과 증상, 예방 방법에 대해 자세히 알아보고, 건강한 겨울을 보내기 위한 실천법을 소개하겠습니다.



폐렴 연관 패혈증
겨울철 가장 흔한 감염 질환 중 하나가 바로 폐렴입니다. 특히 독감(인플루엔자)에 걸린 후 폐렴으로 발전하는 경우가 많고, 면역력이 약한 사람들은 세균성 폐렴이 패혈증으로 진행될 위험이 큽니다.
• 원인: 폐렴구균, 황색포도상구균, 인플루엔자 바이러스 감염 후 2차 세균 감염
• 증상: 고열, 오한, 호흡 곤란, 기침, 가래, 가슴 통증, 의식 저하
• 예방법: - 독감 예방접종 및 폐렴구균 예방접종 필수 (특히 65세 이상, 만성질환자)
- 감기 증상이 심해지고 고열이 지속되면 즉시 병원 방문
- 외출 후 손 씻기, 마스크 착용 등 개인위생 철저



요로 감염 연관 패혈증
겨울철에는 수분 섭취가 줄어들고 활동량이 감소하면서 요로 감염 위험이 증가합니다. 특히 고령자, 당뇨병 환자, 면역 저하자는 요로 감염이 쉽게 패혈증으로 악화될 수 있습니다.
• 원인: 대장균, 장내 세균 감염
• 증상: 배뇨 시 통증, 혈뇨, 고열, 허리 통증, 오한, 피로감
• 예방법: - 하루 1.5~2L 이상 물을 충분히 마셔 요로 정체 예방
- 배뇨 시 통증이나 열이 나면 지체하지 말고 병원 방문
- 면역력이 약한 사람은 요로 감염 예방을 위해 청결 유지



피부 감염(연조직 감염) 연관 패혈증
겨울철에는 피부가 건조해지면서 작은 상처가 생기기 쉽습니다. 피부 상처를 통해 세균이 침입하면 심한 경우 패혈증으로 이어질 수 있습니다. 특히 당뇨병 환자는 당뇨발(당뇨병성 족부궤양)으로 인해 감염이 악화될 위험이 큽니다.
• 원인: 포도상구균, 연쇄상구균 감염
• 증상: 피부 발적, 부기, 통증, 열감, 고열, 쇼크 증상
• 예방법: - 피부 건조 방지를 위해 보습제 사용 및 상처 관리 철저
- 피부 상처 부위가 붓거나 붉어지면 즉시 병원 방문
- 당뇨 환자는 발 관리(상처 확인, 보습, 위생관리) 필수



장염·식중독 연관 패혈증
겨울철에도 식중독균이나 바이러스 감염으로 인해 패혈증이 발생할 수 있습니다. 특히 노로바이러스는 낮은 온도에서도 활발하게 활동하며, 겨울철에도 감염 위험이 큽니다.
• 원인: 노로바이러스, 살모넬라, 장염비브리오
• 증상: 심한 구토, 설사, 탈수, 복통, 발열
• 예방법: - 음식 조리 전·후 손 씻기, 위생 철저
- 익히지 않은 음식(굴, 육회 등) 섭취 시 주의
- 구토, 설사, 고열 증상이 심하면 병원 방문
패혈증 예방을 위한 생활 수칙
• 감염병 예방 접종 필수 (독감, 폐렴구균 예방접종)
• 충분한 수분 섭취로 요로 감염 예방
• 손 씻기, 마스크 착용 등 개인위생 철저
• 건강한 식습관 유지 (면역력 증진)
• 피부 상처 관리 및 감염 의심 시 신속한 병원 방문

예방이 최선! 감염 초기 신속대응이 중요
겨울철에는 추운 날씨와 면역력 저하로 인해 감염병이 쉽게 발생하고, 이것이 패혈증으로 발전하면 치명적인 결과를 초래할 수 있습니다. 특히 고령자, 만성질환자, 면역 저하자는 감염 예방이 더욱 중요하며, 작은 감염도 방치하지 말고 초기에 치료해야 합니다.

패혈증은 빠르게 진행되므로 ①조기 발견과 신속한 치료가 생명을 살릴 수 있습니다. 평소② 감염 예방 수칙을 철저히 지키고, ③감염 증상이 나타나면 즉시 병원을 방문하는 것이 가장 중요한 대응법입니다. 이번 겨울, 건강한 생활 습관을 실천하여 패혈증 위험으로부터 안전하게 지내세요!
겨울철 감염병 노로바이러스 증상 치료 예방법
노로바이러스는 가장 흔하면서도 과소평가된 건강 위협하는 질병 중 하나이며, 특히 겨울철에 그렇습니다. 이 전염성이 매우 강한 바이러스는 오염된 음식, 물, 표면, 심지어 사람과 사람 간의
woori.ssugaengi.com
겨울철 2배 노로바이러스 증상 원인 비대면 치료
겨울이면 많은 사람들이 즐겨 먹는 굴. 특히 김장철과 맞물려 많은 분들이 김치, 보쌈과 함께 생굴을 즐겨드시곤 하는데요. 이처럼 굴의 수요가 늘어나는 만큼 노로바이러스 환자도 함께 증가하
nehi.ssugaengi.com

